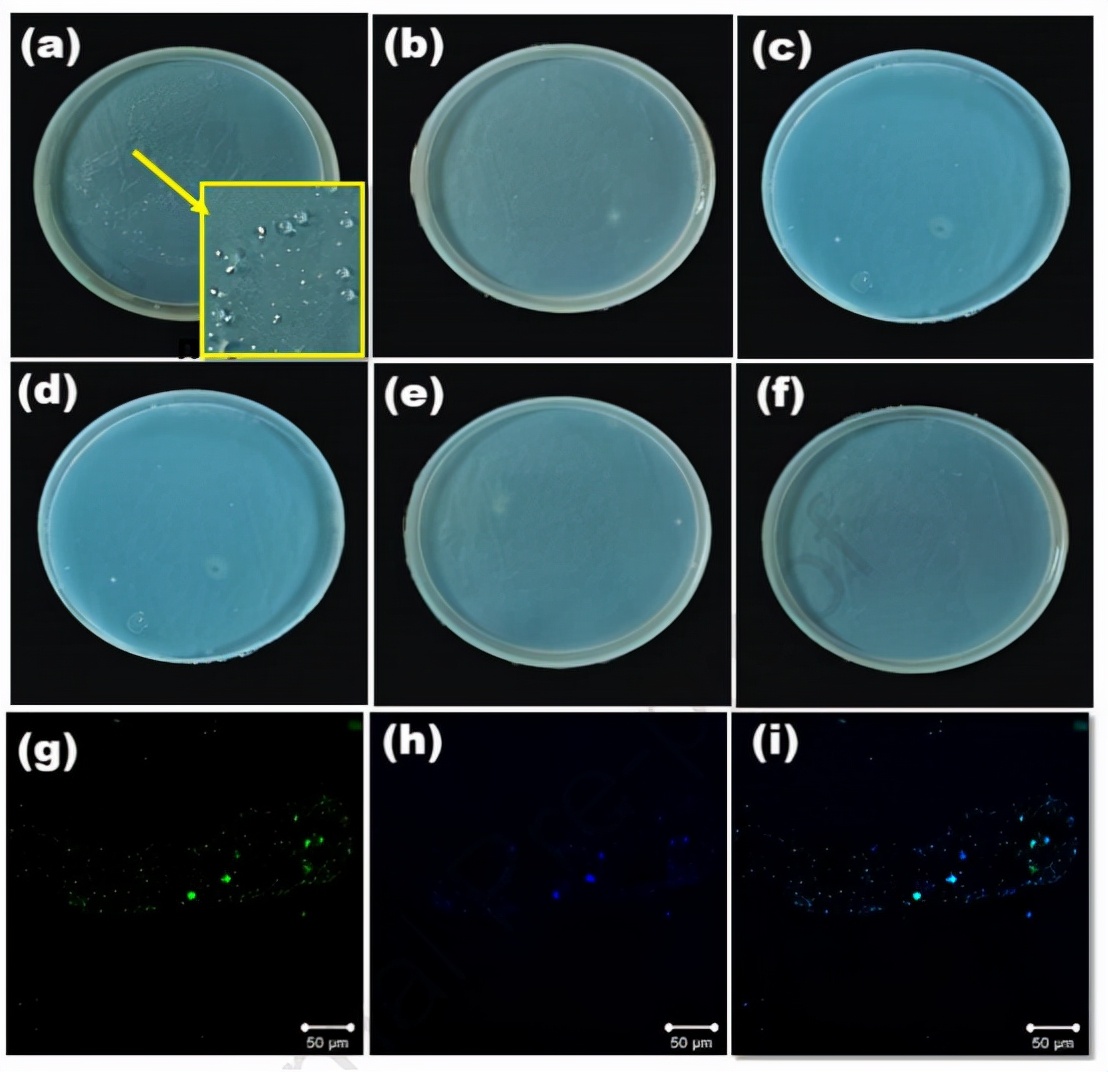
PLLA-Ag@石墨烯复合材料的制备及其在水体污染修复中的应用

Chemosphere:PLLA-Ag@石墨烯复合材料的制备及其在水体污染修复中的应用
DOI: 10.1016/j.chemosphere.2021.131691
规定生活用水不含任何微生物、有机和无机污染物是非常必要的。因此,迫切需要开发出一种可持续、高效、经济且稳健的水净化技术,其可以使用纳米材料及其复合材料来实现。纳米结构石墨烯具有独特的特性,例如高表面积与体积比、较高的吸收性、可重复使用、最小的化学变化以及较低的细胞毒性。通过对这些特性的验证,研究者开发了一种三明治结构PLLA-Ag@石墨烯作为水净化应用的有效吸附物。由于真实水体中含有大量细菌污染物,因此该材料应设计成具有抗菌功效的高效吸附物。为了实现上述目标,研究者采用静电纺丝法合成了PLLA纤维垫,随后制备出PLLA-石墨烯和银修饰PLLA-石墨烯垫。经计算,石墨和Ag@石墨烯的微晶尺寸分别为30.82nm和43.79nm。此外,Ag@石墨烯的UV分析显示285nm和407nm处对应于石墨烯和AgNP的两个峰。这些材料层按照聚合纤维、生物质烧结石墨、Ag@石墨烯的顺序组装,用于系统过滤。使用污染水测试滤液的过滤效率,结果显示过滤后污染物去除率高达87%,且TDS值符合饮用水标准。抗菌功效的结果也证实了该混合系统在水净化应用方面的潜力。

图1.(a)由生物质制备烧结石墨,(b)吸附物的组装层,(c)三明治结构水滤液的制备。

图2.(a)电纺PLLA纤维,(b)由生物质制备的石墨,以及1000-1800cm-1之间(c)Ag@石墨烯(ID<IG)和(d)Ag@石墨烯(解卷积)的拉曼光谱。

图3.(a)PLLA纤维,(b)由生物质制备的烧结石墨和(c)Ag@石墨烯的FTIR光谱,以及相应材料中存在的*能官**团。(d)Ag修饰石墨烯的UV-Vis光谱,插图为烧结石墨。

图4.表面形态图像:(a)石墨表面显示皱纹结构,(b)银修饰石墨烯纳米片。(c)Ag@石墨烯的TEM图像,(d)根据直方图计算出AgNPs的平均粒径为35nm。(e)电纺PLLA纳米纤维的SEM显微照片,(f)根据直方图计算出平均纤维直径为0.57µm。(g)PLLA纤维和(h)Ag修饰石墨烯的EDX光谱。

图5.(a)污水净化设备的内部构造照片和示意图,(b)过滤前(n=0)和过滤后(n=5)的污水比较,(c)使用配备PLLA-Ag@石墨烯的过滤设备时,细菌吸附的归一化UV-Vis光谱,(d)五个过滤稳定性循环的污染率以及标准差。
图6.(a)原始进料溶液的细菌菌落(n=0),插图为放大部分。将已过滤水中存在的细菌在37℃下置于琼脂上生长8天:(b)n=1,(c)n=2,(d)n=3,(e)n=4,(f)n=5。使用(g)肌动蛋白绿(λex=488nm,λem在495-630nm之间)和(h)NucBlue(λex=405nm,λem在410-495nm之间)染色的n=0细菌的共聚焦图像;(i)(g)和(h)的合并图像。
文章来源:北京永康乐业公司 //www.biofabrication.cn/
文章链接:http://www.biofabrication.cn/peixunzhinan1_tal/1399.html